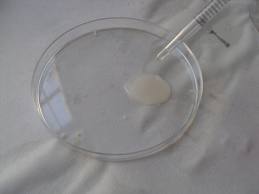

|
Investigación Mexicana
|
|||
|
El desarrollo de redes neuronales es posible gracias a la investigación mexicana.
4° Congreso Internacional
Un Nuevo Concepto de Salud.
|
|||

| |||